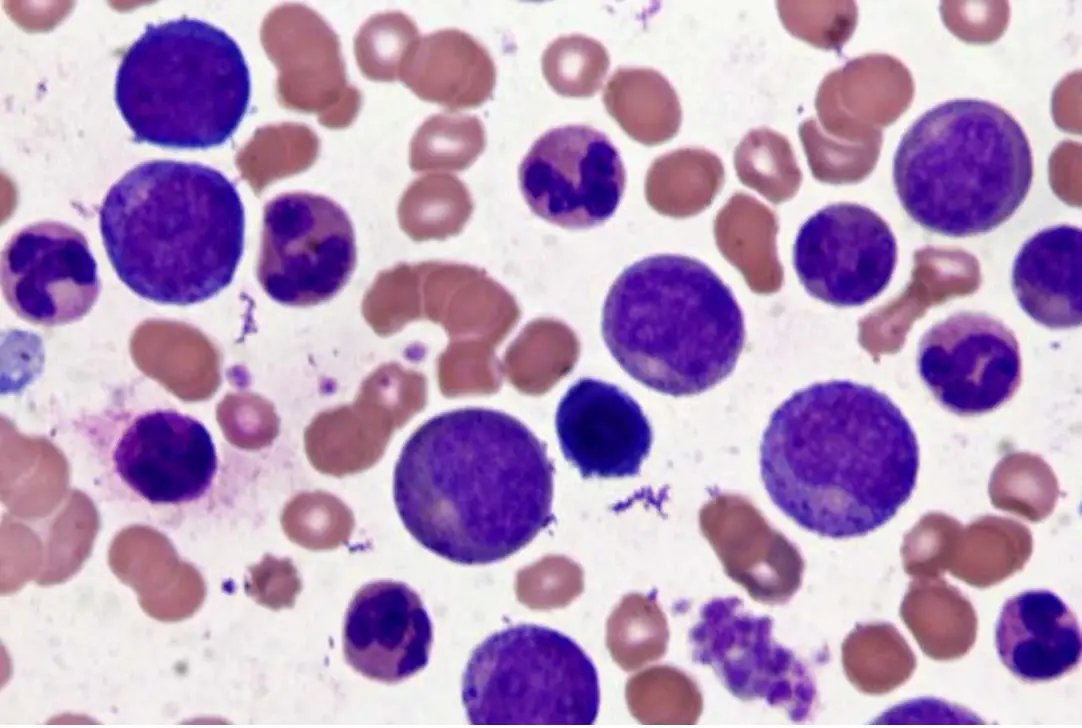
圖片描述

104年:內專
一位38歲病患,健康檢查時發現白血球數目增高,血液抹片如圖所示,此病人白血球增高最可能的原因為何?
A急性骨髓性白血病
B慢性骨髓性白血病
C急性淋巴芽細胞白血病
D慢性淋巴芽細胞白血病
E反應性白血球增生
詳細解析
本題觀念:
根據周邊血液抹片(peripheral blood smear)的形態特徵,鑑別診斷白血球增生的原因,重點辨別慢性骨髓性白血病(chronic myeloid leukemia, CML)與其他白血球增生疾病的典型血液學表現。
影像分析:
圖片為 Wright-Giemsa 染色的周邊血液抹片,高倍鏡下可見以下特徵:
- 顯著白血球增多:視野中白血球密度明顯高於正常,紅血球相對稀少。
- 粒細胞系列全譜呈現(left shift 且全階段可見):可辨認從早期前骨髓細胞(promyelocyte)、骨髓細胞(myelocyte)、後骨髓細胞(metamyelocyte)、桿狀核(band)到成熟分葉核嗜中性球(segmented neutrophil)的各發育階段,呈現連續性粒細胞成熟譜系。
- 嗜鹼性球(basophil)可見:視野中有紫藍色粗大顆粒的嗜鹼性球,為 CML 的重要特徵。
- 母細胞(blast)比例極低:無明顯成群的大型原始細胞,不符合急性白血病的型態。
- 紅血球形態:可見少量正常形態的紅血球,無明顯異形性。
此抹片呈現的「雙峰分布」(骨髓細胞峰 + 成熟分葉核峰)伴隨嗜鹼性球增多,為 CML 慢性期最具特徵性的周邊血液抹片表現。
選項分析
(A) 急性骨
...(解析預覽)...

升級 VIP 解鎖圖文解析